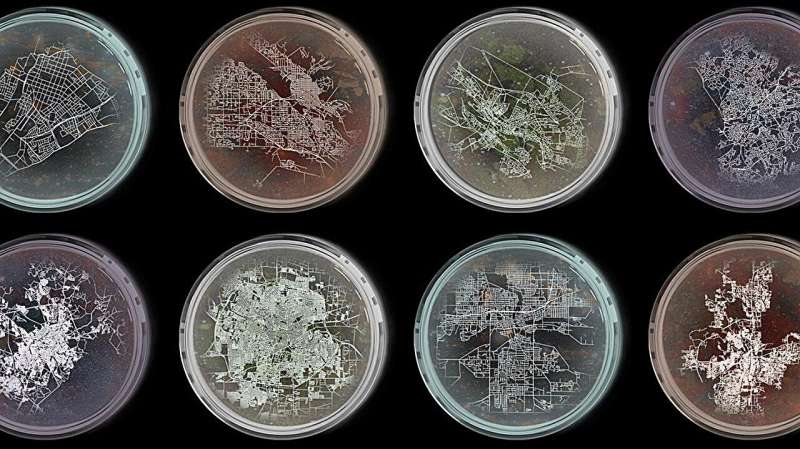

Міста функціонують як живі організми, стверджують вчені EPFL, демонструючи універсальні закономірності міської еволюції.
Дослідження, нещодавно опубліковане в Proceedings of the National Academy of Sciences, виявило: попри відмінності в розмірах, географії та культурі, міста мають схожі “метаболічні” закономірності, що повторюються по всьому світу.
Команда під керівництвом Габріеле Манолі з Федеральної політехнічної школи Лозанни (EPFL) аналізувала мільйони точок даних із понад 100 міст. Вони порівнювали:
- Населення — як масу організму;
- Викиди CO? — як рівень метаболізму;
- Дорожню інфраструктуру — як кровоносну систему.
Усі ці змінні демонстрували ідентичні криві масштабування після нормалізації. Це означає, що міста підкоряються тим самим математичним закономірностям, що й живі системи, зокрема за аналогією до закону Клейбера, що описує енергетичну ефективність організмів залежно від їхнього розміру.
Ключовий висновок:
“Великі міста не обов’язково більш сталi. Економічна діяльність, щільність населення і транспорт – взаємопов’язані, і лише в поєднанні вони формують дійсно стійке середовище”, — зазначає Манолі.
Для точнішого аналізу дослідники поділили міста на “пікселі” — мікрорайони, й застосували підхід масштабування кінцевого розміру, розроблений для врахування локальних варіацій, аналогічно до індивідуальних відмінностей між тваринами в біології.
Це дослідження закликає урбаністів переосмислити планування, виходячи з динамічної, біоподібної природи міст. Системний підхід, що враховує взаємозалежність компонентів, стає ключем до створення більш стійких і адаптивних урбанізованих територій.
#Міста #розвиваються #як #живі #організми
Source link